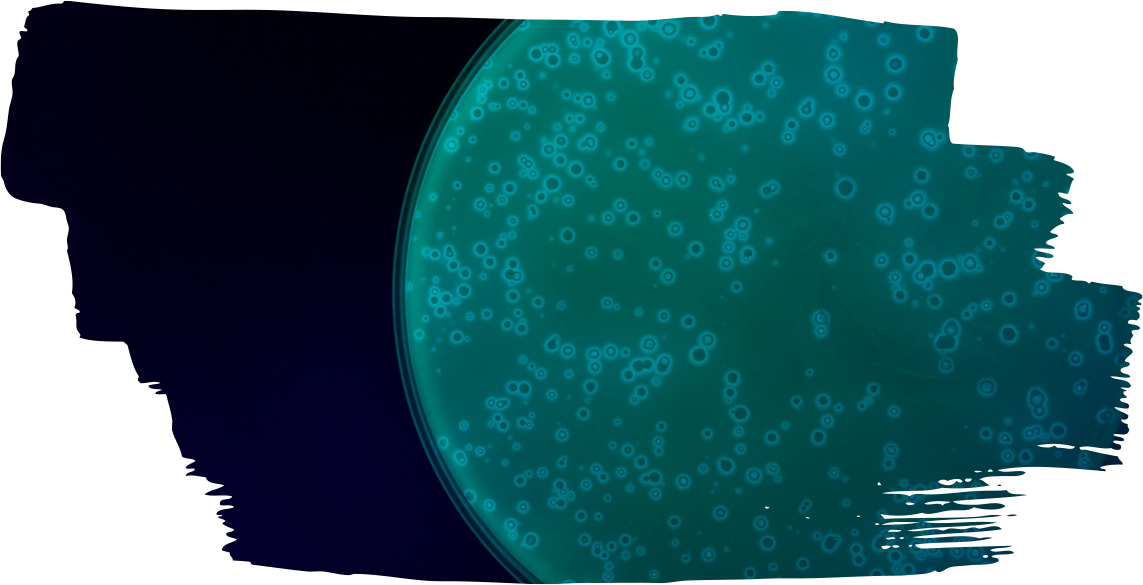

Research
How can we use Machine Learning, Big Data and Genomics to predict the future of antibiotic resistance?
Can antibiotic resistance be reversed?
How does the intricate network of interactions among species shape ecosystem diversity, dynamics and stability?

PATHOGEN GENOMICS

From pathogen genomics to resistance-proof drug regimes
In the chemical warfare between bacteria and humans, the clinical use of antibiotics drives higher resistance levels by selecting for resistant bacteria. To make antibiotic treatment resilient to the evolution of resistance, one has to understand the ways in which bacteria evolve and become resistant, and identify the genomic determinants which potentiate them.
Our long term goal is to help design single-drug and multi-drug regimes that better prevent the emergence of resistance. In the lab and in the clinic, we follow bacteria as they are becoming more resistant, identifying the underlying mutations which enable these phenotypes and explore their dynamics on different genetic backgrounds and in different environments. In the future, these insights will allow genome-based “anticipatory” diagnostics of microbial infections that can predict future evolution and help prescribe more resilient antimicrobial treatments.
Digital Health


From big-data and machine-learning to personalized antibiotic treatment
Antibiotic drugs save human lives threatened by infections, but their effectiveness is hindered by antibiotic resistance. In the clinic, physicians face the challenge of prescribing the most effective antibiotic drug under conditions of uncertainty. Unique availability of millions of electronic health records and pathogen genomes, now allows us to develop a new kind of machine learning-based diagnostics algorithms that predict the current and future infection-specific profile of resistance,
and suggest an optimized personally-tailored treatment. We are currently pursuing the development of more powerful and comprehensible algorithms which will provide the basis for advanced data-driven decision support systems which will suggest optimized treatment in real-time. These future systems have the potential to improve individual patient treatment outcomes and overall patient health, while at the same time helping in the global effort to impede the antibiotic resistance epidemic.
ECOLOGY & EVOLUTION


From species evolution and species interactions to whole community dynamics and stability
In natural ecosystems bacteria grow, migrate and compete over nutrients in dense and diverse communities. In such communities, antibiotic production and antibiotic resistance genes evolve in a continuous arms race. Our goal is to identify the principles governing the evolution, maintenance and refinement of these antibiotic-based interactions.
Allowing bacteria to co-evolve in laboratory settings we follow the role of evolution in shaping such multi-bacterial communities. Encapsulating competing species in artificial microenvironments we challenge bacteria to enhance toxicity and explore the evolutionary pathways leading on one hand to increased antibiotic resistance and on the other hand to improved antibiotic production.